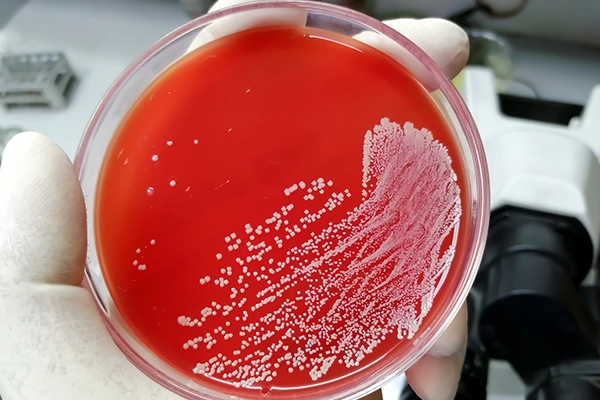

Elevating Confidence with Molecular Quality Controls

Don’t let a joint infection become serious. Test your patients. Our BioFire® JI Control Panel M420 contains synthetic DNA of 39 bacteria, yeast, and antimicrobial resistance genes most often associated with joint infections, all in 1 tube, so you can ensure the right diagnostic and treatment.

Our #1 Best Seller for years for respiratory diseases testing. By far the most coveted product of our portfolio, our BioFire® RP2.1/RP2.1plus Control Panel M441 is a synthetic multiplex quality control that monitors the detection of pathogens associated with respiratory infections
Enhanced Formulation. We have reviewed and optimized the formulation of our FilmArray® BCID2 Positive Control Panel M416 in close collaboration with our partner bioMérieux.

Get the right gastroenteritis diagnostic for your patients. FilmArray® GI Control Panel M238 is comprised of synthetic RNA to monitor the detection of 22 gastrointestinal pathogens in just one single tube.

Make the right diagnosis to ensure timely treatment. Our FilmArray® Ebola Control Panel M251 can help ensure accurate results for your patients in the detection of the Ebola Zaire virus.

Make the distinction between viral and bacterial pneumonia. Our FilmArray® Pneumonia/ Pneumoniaplus Control (M340) is composed of synthetic RNA and DNA to monitor the detection of clinically relevant targets for pneumonia diagnostic.

14 targets in 1 tube? That’s a no-brainer. BioFire® ME Control Panel M262 contains synthetic RNA to monitor the detection of the most common bacterial, viral, and fungal causes of central nervous system infections.

Point-of-care testing is fast, but also needs to be accurate. Our multiplex SPOTFIRE® RSP Pos & Neg Controls cover all 4 respiratory assays on the BIOFIRE SPOTFIRE System with one single tube.

Vector-borne tropical diseases present with similar non-specific symptoms, but require different targeted treatments. Our FilmArray® TF Control Panel M527 is composed of synthetic DNA and RNA corresponding to genome segments of all 6 pathogens included in the assay to ensure accurate detection for your patients.